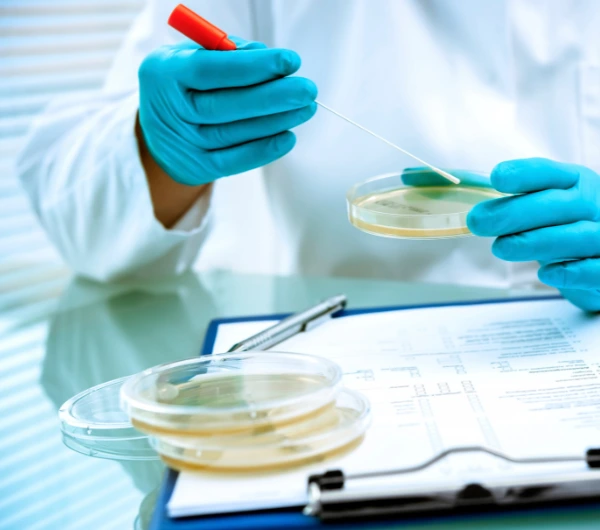

MANAGEMENT SYSTEM CERTIFICATION
At International Associates, we offer more than just certifications. Our Management System Certifications are designed to enhance operational excellence and foster continuous improvement beyond basic compliance. They represent a commitment to elevating every aspect of your business.
Our diverse range of certifications is specifically developed to improve various areas of your organization, from quality management to environmental responsibility and information security. We ensure your business not only meets but exceeds global standards.
Join us on a journey of transformation with International Associates. Discover how our certifications can align with your strategic goals to drive growth, build resilience, and create a culture of excellence within your organization.
SERVICES OFFERED
For more information about our services please contact us by using our contact form, by phone or drop us an email. We will be pleased to assist you.
Alternatively get a quote by filling in our enquiry form